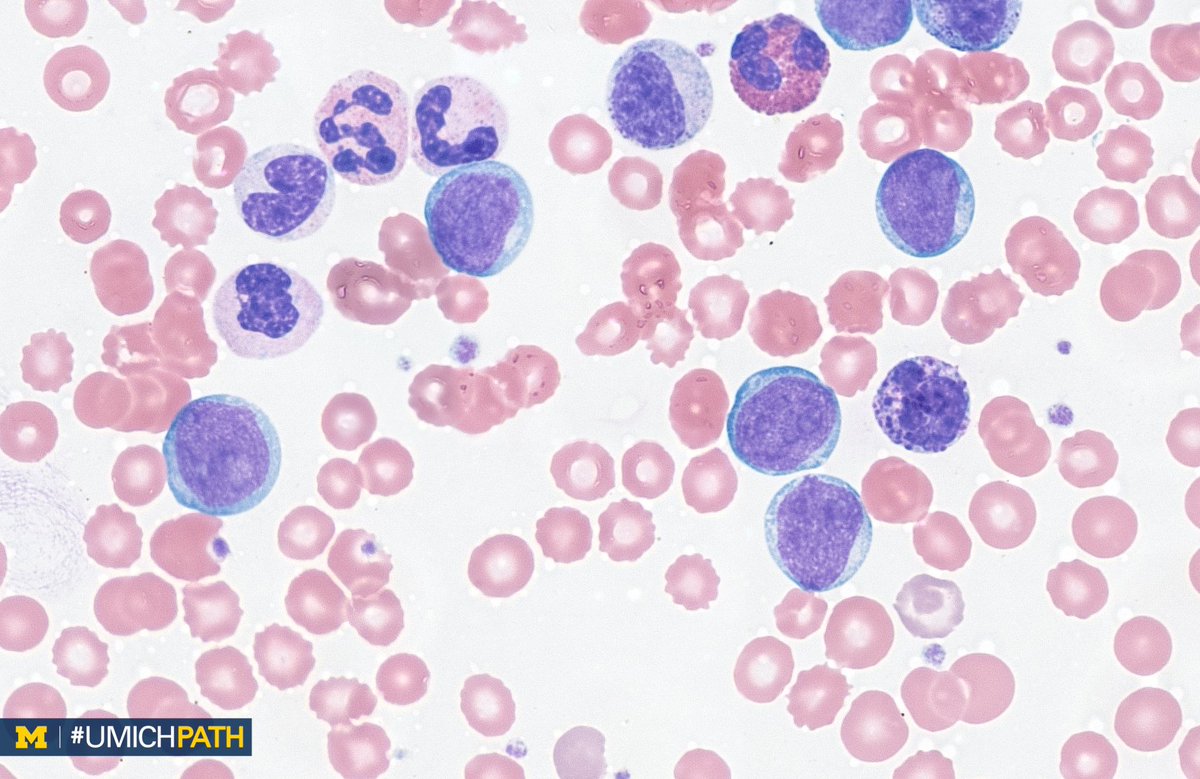

Certified Vet Tech Salary In Pa
The average hourly pay for a certified veterinary technician (cvt) in pittsburgh, pennsylvania is $18.28. New certified veterinary technician careers are added daily on simplyhired.com.

7c2baea05e874705ea347d277e6f381e.jpg (736×952) Operating
In may 2017, vet techs made a median salary of $34,710, while vet assistants earned a lower median salary of $27,570;

Certified vet tech salary in pa. 3,353 certified veterinary technician jobs available on indeed.com. And because fewer people are working as veterinary technicians today than in the past, there is an incredibly high demand for them. Salaries estimates are based on 15 salaries submitted anonymously to glassdoor by certified veterinary technician employees in pittsburgh, pa.
Annual salary monthly pay weekly pay hourly wage; Have 10,000 hours of experience (with 75 percent in chosen specialty); Complete 40 hours of ce;
Before we get into the national average for vet tech salary, it’s important to remember that every facility, situation, and job will be different and will have different factors. The average certified veterinary technician salary in massachusetts is $39,200 as of may 27, 2021, but the range typically falls between $33,000 and $46,600. Canine/feline, exotic companion animal, or production animal.
To be certified as a clinical practice vet tech, a candidate must have at least 10,000 hours (five years) of experience, 50 case logs, four case reports, and 40 hours of documented continuing education. Salary ranges can vary widely depending on the city and many other important factors, including education, certifications, additional skills, the number of years you have spent in your profession. 1 year of veterinary experience.
The middle 80% of vet techs earn between $21,890 and $47,410. Send a case log with at least 50 cases & four case reports; The top half of these veterinary professionals made more than these figures, while the bottom half earned less.earnings for the lower 10 percent was less than $22,880 for vet techs and $19,110 for vet assistants.
See salaries, compare reviews, easily apply, and get hired. Submit a skills assessment & knowledge list; The median salary for veterinary technicians in pennsylvania is $34,720 per year.
This is higher than the median nationwide annual salary for vet techs, which is $32,350. Get one letter of recommendation; On 91 salaries submitted anonymously to glassdoor by veterinary technician employees in philadelphia, pa.
The lead veterinary technician, supervises and assists technicians, and will report directly to the practice manager and…. A vet tech's salary tends to be higher than a vet assistant's salary. The average salary for a veterinary technician is $35,985 in philadelphia, pa.
Working as a vet tech provides you with a kind of job security that few other professions typically offer. Art city vets & urgent care 3.0. 1,594 certified veterinary technician jobs available.
The annual median salary for a vet tech in the u.s. There are over 1,594 certified veterinary technician careers waiting for you to apply! Social advocacy organizations like humane societies had median pay of $33,080 and private services paid a median salary of $33,010.
Apply to veterinary technician, veterinary assistant and more! The average entry level salary in 2018 for vet techs was $29,993. According to research from 1salary, it’s reported that vet techs will make a median base salary of about $36,394.
How much does a certified veterinary technician make in pittsburgh, pa? The average salary for a certified veterinary technician is $30,678 in pittsburgh, pa. And pay an application fee.
Salaries for related job titles. In fact, the job outlook for vet techs will grow by a whopping 20% by 2026. The veterinary technicians and technologists are educated to be the veterinarian’s nurse, laboratory technician, radiography technician, anesthetist, surgical nurse and client educator.
Provide five completed examination questions; The middle 80% of vet techs earn between $21,890 and $47,410. A veterinary technician’s salary will depend on a number of factors including education qualifications, work experience, type.
To qualify, candidates must provide proof of state vet tech credentialing; The average annual wage of vet tech stands at $32,426, while the hourly wage is approximately $16.08. The vet tech assists the veterinarian in every aspect of animal care, including animal intake and discharge, and record keeping.
Such a trend offers good news to prospecting students looking to enter the animal care field by applying to vet tech schools or considering online vet tech programs. Clinical practice vet techs provide care to animals in one of three subspecialty areas: Many veterinary technicians and technologists are placed in a supervisory role in veterinary practices, research institutions and other employment options.

An easy way to differentiate the fibula and tibia! Tech

Pin by Carroll Odem on Hematology Hematology, Cancer

What is the role of an operating room nurse? How to

Clipboards WhiteCoat Clipboard Pharmacy Label Nursing

Example of a surgeons preference card Operating room

fd6af0189a2ba9d88f9ca3464e09d1c2.jpg (736×389) Medical

My Notes for USMLE THALASSEMIAS Medical laboratory

veterinary salary College Planning Pinterest

Nurse Salary NursePractitionerSchooling Nursing school

Pin by pritam pal on study material for veterinarian

surgical technology MedicalTechnology in 2020 Medical

Dental Hygienist mean wage May 2011 Dental hygienist

Interested in a PT Assistant? Here's an overview

Meaningful Use Stage 2 Final Rule Overview Medical

fd6af0189a2ba9d88f9ca3464e09d1c2.jpg (736×389) Medical

Pin by pritam pal on study material for veterinarian
Pin by Carroll Odem on Hematology Hematology, Cancer

FunnyTShirtsAzBetter" Cool shirts, Tech t shirts

Post a Comment for "Certified Vet Tech Salary In Pa"